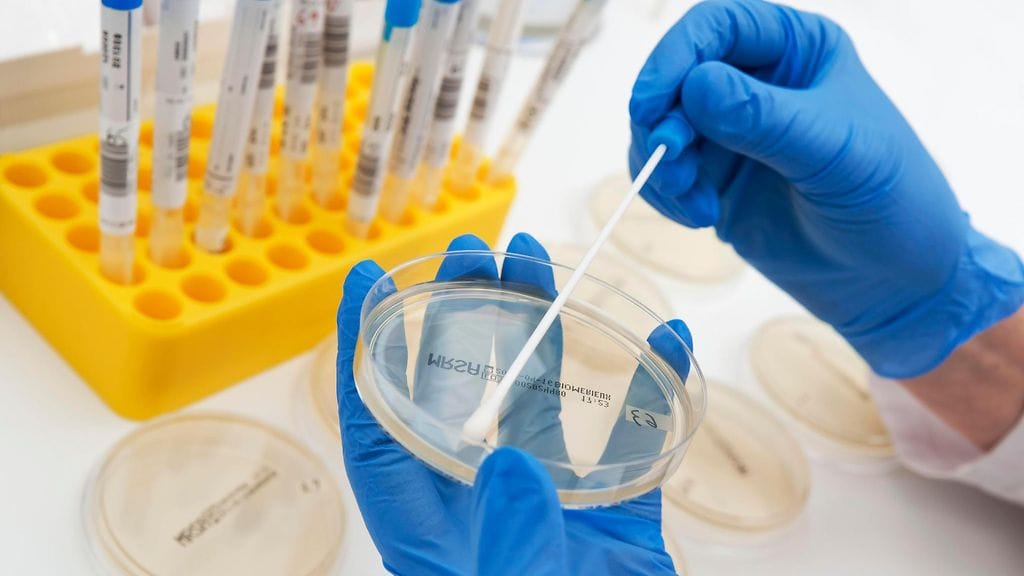
Satoja altistunut listerialle tukholmalaisravintolassa. Kuvituskuva

Mahdollisia listeriaan sairastuneita on satoja.
Tukholmassa 15 henkilöä on joutunut sairaalaan sairastuttuaan listerioosiin, uutisoi muun muassa Ruotsin yleisradio SVT.
Henkilöt ovat syöneet Coco & Carmen -nimisessä luksusravintolassa Tukholman Östermalmilla.
Syyskuun lopulla ravintolassa syöneiltä henkilöiltä on tällä hetkellä tullut 80 ruokamyrkytysilmoitusta Tukholman kaupungin elintarviketurvallisuusviranomaiselle.
Tartuntatautilääkäri Maria Rotzén Östlund kertoo SVT:lle, että neljä hoidettavasta potilaasta on saanut sepsiksen, eli verenmyrkytyksen, mutta kukaan ei ole tarvinnut tehohoitoa.
– Oireina ovat ennen kaikkea korkea kuume, ripuli ja oksentelu, hän toteaa.
Lue myös: Ikävä havainto ravintola- ja markettisusheista: "Hyvä tiedostaa..."
SVT:n mukaan mahdollisia potilaita on jäljitetty aikavälillä 23.–27.syyskuuta ja noin 400 ravintolan asiakasta on kontaktoitu.
Rotzén Östlundin mukaan potilaiden tila vaihtelee ja osalla oireet ovat jo hävinneet.
– Sepsiksen saaneet ovat vakavammassa tilassa, mutta en voi sanoa tarkasti, kuinka kauan heidän on oltava sairaalassa.
SVT:n mukaan ravintolasta saadut listeriatapaukset ovat harvinaisia.